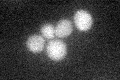
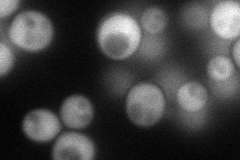
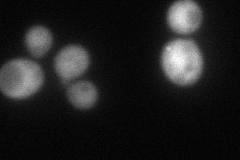
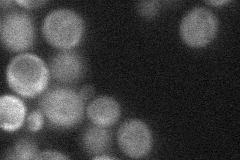
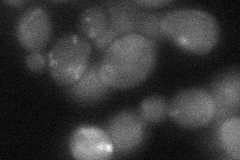
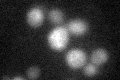
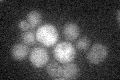

View description
Type 2C protein phosphatase (PP2C); inactivates the osmosensing MAPK cascade by dephosphorylating Hog1p; mutation delays mitochondrial inheritance; deletion reveals defects in precursor tRNA splicing, sporulation and cell separation
Localization:
Intensity:
Fold change:
Significance:
-
C’ GFP library in SD
cytosol20.38 -
N' NOP1pr-GFP in SD
cytosol95.4147 -
N' TEF2pr-mCherry in SD
punctate,nucleus80.1304 -
N' NATIVEpr-GFP in SD
cytosol39.921 -
N' TEF2pr-VC and Cyto-VN in SD
cytosol35.26 -
C’ GFP library in SD+DTT
cytosol17.870.87No -
C’ GFP library in SD+H2O2

cytosol18.280.89No -
C’ GFP library in Starvation Media
cytosol17.340.85No -
C’ GFP library on the background of Pup2-DaMP

cytosol -
C’ GFP library on the background of CCT mutant

cytosol21.85161.07185No
